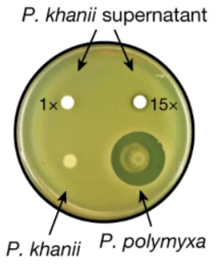

Media Manager
Media Files
Files in [root]

- 捕获.png
- 1422×648
- 2022/02/27 18:12
- 1.1 MB

- 1._cryo-electron-microscopy-em-work-flow-a-purified-sample-is-applied-to-the-grid-and.png
- 850×525
- 2021/03/01 17:37
- 122.5 KB

- 1.gif
- 1280×720
- 2023/02/01 21:33
- 23.3 MB

- 1.png
- 950×272
- 2021/03/01 14:40
- 82.3 KB

- 1a.png
- 482×138
- 2021/02/28 15:44
- 23.4 KB

- 1b.png
- 760×261
- 2021/03/01 01:41
- 51.2 KB

- 1b2.png
- 760×261
- 2021/03/01 01:42
- 51.2 KB

- 1c.png
- 402×340
- 2021/02/28 16:03
- 92.1 KB

- 1ca.png
- 402×340
- 2021/02/28 16:04
- 92.1 KB

- 1d.png
- 439×320
- 2021/02/28 15:44
- 39.8 KB

- 1e.png
- 1045×310
- 2021/02/28 15:44
- 310.4 KB

- 1envelope.png
- 720×504
- 2023/01/31 23:25
- 111.5 KB

- 1f.png
- 391×342
- 2021/02/28 15:44
- 28.7 KB

- 1g.png
- 355×309
- 2021/02/28 15:44
- 100.6 KB

- 2._cryo-em_structures_of_the_sars-cov-2_s_glycoprotein_in_complex_with_the_s309_neutralizing_mab_fab_fragment..png
- 711×291
- 2021/03/01 17:37
- 231.5 KB

- 2.gif
- 1280×720
- 2023/02/01 21:34
- 37.8 MB

- 2.png
- 512×147
- 2021/03/01 14:41
- 32.5 KB

- 2figure_1.png
- 592×436
- 2023/03/01 21:24
- 42.5 KB

- 2figure_2.png
- 412×710
- 2023/03/01 21:24
- 234.3 KB

- 2figure_3.png
- 714×548
- 2023/03/01 21:24
- 248.2 KB

- 2figure_4.png
- 704×294
- 2023/03/01 21:24
- 238.2 KB

- 2figure_5.png
- 496×342
- 2023/03/01 21:24
- 74.9 KB

- 2figure_6.png
- 420×444
- 2023/03/01 21:24
- 147.2 KB

- 2figure_7.png
- 446×394
- 2023/03/01 21:24
- 194.9 KB

- 2figure_8.png
- 370×392
- 2023/03/01 21:24
- 92.2 KB

- 2figure_9.png
- 936×352
- 2023/03/01 21:24
- 184.2 KB

- 2figure_10.png
- 500×554
- 2023/03/01 21:24
- 180 KB

- 2figure_11.jpg
- 332×418
- 2023/03/01 21:24
- 17 KB

- 2figure_12.png
- 648×328
- 2023/03/01 21:24
- 94.9 KB

- 2figure_13.jpg
- 360×398
- 2023/03/01 21:24
- 38.4 KB

- 2figure_14.png
- 670×254
- 2023/03/01 21:24
- 143 KB

- 2figure_15.png
- 460×592
- 2023/03/01 21:24
- 186.4 KB

- 2figure_16.png
- 584×356
- 2023/03/01 21:24
- 199.9 KB

- 2figure_17.png
- 778×316
- 2023/03/01 21:24
- 112.6 KB

- 2figure_18.png
- 936×366
- 2023/03/01 21:24
- 87.4 KB

- 2table_1.png
- 936×540
- 2023/03/01 21:24
- 67.5 KB

- 3._close-up.png
- 785×474
- 2021/03/01 17:37
- 344.4 KB

- 3.png
- 512×113
- 2021/03/01 14:44
- 27 KB

- 4._s309_epitope_conservation.png
- 491×606
- 2021/03/01 17:37
- 213.9 KB

- 4.png
- 512×117
- 2021/03/01 14:49
- 53.7 KB

- 4c03_2021_winter_term.png
- 390×898
- 2022/04/08 15:50
- 105.5 KB

- 4c03_2022_class_list_v4.png
- 756×1058
- 2022/01/19 16:15
- 224.3 KB

- 4c03_2023.png
- 1180×808
- 2023/01/12 12:55
- 246.9 KB

- 4c03_group_2_presentation_1.pdf
- 2022/02/02 23:17
- 1.7 MB

- 4d.png
- 389×177
- 2023/03/02 02:21
- 29.7 KB

- 5._conserved_region.png
- 1674×550
- 2021/03/01 17:37
- 601.6 KB

- 5.png
- 512×93
- 2021/03/01 14:54
- 29.4 KB

- 5ab.png
- 1636×761
- 2021/03/01 22:46
- 256.7 KB

- 5cde.png
- 1077×842
- 2021/03/01 23:15
- 1.4 MB

- 6.png
- 966×353
- 2021/03/01 15:15
- 238.4 KB

- 6a.png
- 732×343
- 2021/03/02 00:08
- 75.2 KB

- 6b.png
- 747×383
- 2021/03/02 00:08
- 91.5 KB

- 6cd.png
- 408×753
- 2021/03/02 00:08
- 93 KB

- 7.png
- 512×136
- 2021/03/01 15:33
- 47.2 KB

- 7a.png
- 1054×250
- 2021/03/02 02:57
- 81.1 KB

- 7bc.png
- 1056×514
- 2021/03/02 02:59
- 154.8 KB

- 7de.png
- 1094×503
- 2021/03/02 03:00
- 154 KB

- 8.png
- 1600×275
- 2021/03/01 15:38
- 165.6 KB

- 9.png
- 676×540
- 2021/03/01 15:52
- 415.9 KB

- 9f.png
- 286×232
- 2023/03/02 02:21
- 31.9 KB

- 10.png
- 855×263
- 2021/03/01 15:46
- 155.9 KB

- 11.png
- 1600×985
- 2021/03/01 15:48
- 630.7 KB

- 12.png
- 1600×782
- 2021/03/01 15:54
- 317.6 KB

- 13.png
- 375×375
- 2021/03/01 15:58
- 88.6 KB

- 14.jpg
- 512×274
- 2021/03/01 16:24
- 46.4 KB

- 15.jpg
- 512×181
- 2021/03/01 16:32
- 29.2 KB

- 16.png
- 512×251
- 2021/03/01 16:37
- 35.7 KB

- 17.jpg
- 471×512
- 2021/03/01 16:40
- 56 KB

- 18.png
- 1295×885
- 2021/03/01 16:52
- 516.4 KB

- 20.png
- 875×249
- 2021/03/01 18:53
- 146.1 KB

- 21.png
- 875×277
- 2021/03/01 18:54
- 161.6 KB

- 22.png
- 1436×855
- 2021/03/01 18:50
- 351 KB

- 24.png
- 875×277
- 2021/03/01 18:57
- 161.6 KB

- 25.png
- 1714×842
- 2021/03/01 18:58
- 281.8 KB

- 25_mabs.png
- 1451×943
- 2021/02/23 13:16
- 746.8 KB

- 26.png
- 1324×647
- 2021/03/01 19:02
- 247.8 KB

- 27.png
- 564×328
- 2021/03/01 19:05
- 106.8 KB

- 28.png
- 1006×278
- 2021/03/01 19:14
- 102.8 KB

- 30.png
- 672×375
- 2021/03/01 19:20
- 134.1 KB

- 31.png
- 922×907
- 2021/03/01 19:25
- 252.5 KB

- 32.png
- 369×512
- 2021/03/01 20:36
- 201.7 KB

- 33.png
- 472×512
- 2021/03/01 20:47
- 119.3 KB

- 123.png
- 697×258
- 2022/01/28 20:48
- 50.8 KB

- 143.png
- 523×271
- 2022/01/27 14:59
- 54.7 KB

- 144.png
- 593×454
- 2022/01/28 05:01
- 40.3 KB

- 211.png
- 1815×826
- 2022/02/27 18:17
- 1.7 MB

- 222.png
- 613×81
- 2022/02/27 18:27
- 10.5 KB

- 223.png
- 979×987
- 2022/02/27 18:36
- 63.2 KB

- 226.png
- 728×335
- 2022/02/27 23:25
- 22.2 KB

- 227.png
- 1883×628
- 2022/02/27 23:23
- 189.5 KB

- 229.png
- 1620×809
- 2022/02/28 00:21
- 161.1 KB

- 232a.png
- 512×297
- 2023/02/01 23:46
- 100.7 KB

- 232b.png
- 512×359
- 2023/02/02 00:09
- 107.7 KB

- 232d.png
- 512×365
- 2023/02/02 00:09
- 151.7 KB

- 232e.png
- 512×493
- 2023/02/02 00:09
- 108.1 KB

- 232f.png
- 512×250
- 2023/02/02 00:09
- 50.2 KB

- 232g.png
- 512×147
- 2023/02/02 00:09
- 26.1 KB

- 978-1-59745-557-2_3_fig1_html.jpg
- 480×301
- 2022/02/28 15:26
- 29.8 KB

- 1223.png
- 1359×599
- 2022/01/28 18:50
- 519.7 KB

- 23311_lores.jpg
- 700×393
- 2021/02/01 13:22
- 30.3 KB

- 41564_2020_789_fig1_html.jpg
- 1999×1384
- 2022/02/27 12:32
- 384.1 KB

- 20200303-conv.jpeg
- 419×327
- 2022/01/21 19:34
- 19.3 KB

- 34143530-8818593-image-m-3_1602153445503.jpg
- 306×391
- 2021/02/26 00:19
- 22.3 KB

- ace.jpg
- 1000×1172
- 2021/02/01 23:00
- 64 KB

- adaptive_immunity_1_.png
- 462×390
- 2021/02/01 13:52
- 96.4 KB

- adcp.png
- 654×464
- 2021/02/27 14:25
- 67.9 KB

- adcp_ali.png
- 1016×682
- 2021/02/28 14:57
- 111.6 KB

- adcp_ali_1.png
- 979×636
- 2021/02/28 15:02
- 110.5 KB

- affinity.png
- 579×394
- 2022/03/02 18:15
- 157.3 KB

- age.png
- 279×390
- 2021/02/01 21:08
- 41.9 KB

- antibiotic_resistance_steps.jpg
- 511×864
- 2023/02/02 00:23
- 60.9 KB

- antibiotics.png
- 884×716
- 2023/01/30 16:19
- 827.4 KB

- antibiotics1.png
- 1724×850
- 2023/01/30 17:26
- 1.7 MB

- antibioticsnew.png
- 884×716
- 2023/01/30 17:10
- 827.4 KB

- antibioticstogether.png
- 1724×850
- 2023/01/30 17:21
- 1.7 MB

- antibodyconcentrations.png
- 1508×624
- 2022/02/03 00:05
- 837.8 KB

- aptamer_1.png
- 326×317
- 2022/02/27 15:43
- 184.8 KB

- b.jpg
- 1200×773
- 2021/02/01 23:16
- 112.4 KB

- bacillus.jpeg
- 400×310
- 2023/01/30 12:21
- 70.6 KB

- bam.png
- 1235×551
- 2023/02/01 19:31
- 650.3 KB

- bama.png
- 1014×1156
- 2023/02/02 00:18
- 1.1 MB

- bamathroughout.png
- 1252×410
- 2023/02/02 00:56
- 554.1 KB

- bamb.png
- 221×190
- 2023/02/02 01:37
- 25.7 KB

- bamc.png
- 276×145
- 2023/02/02 01:49
- 22.8 KB

- bamc2.png
- 238×289
- 2023/02/02 01:56
- 88.4 KB

- bamcomplex.png
- 1390×1092
- 2023/02/02 00:33
- 1 MB

- bame.jpg
- 749×415
- 2023/02/02 04:04
- 121.8 KB

- bamlink.png
- 505×307
- 2023/03/02 08:17
- 118.9 KB

- betabambarrel.png
- 4234×4026
- 2023/02/01 19:31
- 787.2 KB

- beyond_covid-19.png
- 351×512
- 2021/03/01 22:47
- 137.1 KB

- biochem_4c03-presentation_1.pdf
- 2021/02/02 00:33
- 1 MB

- biochemistry_4c03_presentation_2_-_group_3.pdf
- 2022/03/02 22:43
- 4.6 MB

- biochemistry_4c03_presentation_2_-_group_3_updated.pdf
- 2022/03/03 04:24
- 4.6 MB

- biopanning.png
- 589×401
- 2022/03/02 21:17
- 73.6 KB

- bli_1.png
- 1071×756
- 2021/02/23 20:02
- 154.4 KB

- bli_2.png
- 1216×718
- 2021/02/23 20:25
- 73.7 KB

- bli_results.png
- 473×1038
- 2021/02/24 20:29
- 288.4 KB

- capture.jpg
- 790×434
- 2022/01/31 23:52
- 64.6 KB

- capture.png
- 349×371
- 2023/01/25 23:55
- 90.7 KB

- cd4_t_cell.png
- 2432×1258
- 2021/02/28 15:30
- 350.5 KB

- cd4_t_cell_responses.png
- 1743×764
- 2021/03/01 13:14
- 198.3 KB

- challengestain.png
- 489×163
- 2021/03/01 23:48
- 209 KB

- comorbidity.png
- 259×290
- 2021/02/01 21:09
- 21.2 KB

- comparison.png
- 784×504
- 2023/02/15 23:18
- 178.9 KB

- conclusion.png
- 566×417
- 2021/02/01 01:52
- 76 KB

- corona.jpg
- 662×480
- 2023/01/30 18:53
- 64.4 KB

- corona_electron_micrograph.jpg
- 800×625
- 2021/01/31 14:35
- 95.1 KB

- coronaviridae.png
- 531×259
- 2021/02/01 02:27
- 42 KB

- coronaviridae1.png
- 492×228
- 2021/02/01 02:29
- 47.4 KB

- coronavirus-lp-graphic-2.jpg
- 400×247
- 2022/01/26 19:28
- 17.7 KB

- coronavirus_life_cycle.jpg
- 3838×2612
- 2022/01/29 14:09
- 2.1 MB

- coronavirus_structure_-_higher_res.png
- 724×502
- 2021/01/27 15:54
- 361.1 KB

- correlation.png
- 2232×1220
- 2022/03/02 11:39
- 478.8 KB

- covid19_variants_map_bps.jpg
- 1495×1200
- 2022/02/02 20:26
- 232 KB

- covid_image.jpeg
- 700×393
- 2022/01/29 20:13
- 35.3 KB

- covidstructure.png
- 956×663
- 2022/01/30 13:03
- 534.9 KB

- cpt.jpg
- 714×410
- 2021/01/31 17:09
- 60 KB

- crispr_covid.png
- 933×359
- 2021/02/02 00:12
- 77.3 KB

- ct_scan.png
- 468×324
- 2021/02/01 19:21
- 153.9 KB

- cytokinestorm.jpg
- 748×553
- 2022/01/28 15:28
- 106.6 KB

- daro_mechanism1.png
- 854×300
- 2023/03/01 16:57
- 273.5 KB

- daro_mechanism2.png
- 936×466
- 2023/03/01 16:57
- 368.6 KB

- darobactin_-_01.png
- 223×267
- 2023/03/01 14:49
- 70.7 KB

- darobactin_-_02.png
- 846×495
- 2023/03/01 14:56
- 102.9 KB

- darobactin_-_03.png
- 856×458
- 2023/03/01 14:56
- 119.5 KB

- darobactin_-_04.png
- 522×444
- 2023/03/01 14:56
- 49.5 KB

- darobactin_-_06.png
- 643×522
- 2023/03/01 14:56
- 148.3 KB

- darobactin_-_07.png
- 736×612
- 2023/03/01 14:56
- 273.6 KB

- darobactin_-_08.png
- 717×864
- 2023/03/01 14:56
- 171.7 KB

- darobactin_-_09.png
- 496×428
- 2023/03/01 14:56
- 43.4 KB

- darobactin_sidechain_contacts.png
- 708×359
- 2023/03/02 00:01
- 128.8 KB

- darobactin_structure.png
- 1841×752
- 2023/03/01 20:01
- 102 KB

- darobactin_structure_image.png
- 931×386
- 2023/02/01 16:59
- 79.9 KB

- design_pic_1.png
- 1320×922
- 2021/03/01 21:22
- 226.3 KB

- diagnostics_of_sars-cov-2.pdf
- 2021/02/02 01:44
- 1.3 MB

- diagnostics_of_sars-cov-2.pptx
- 2021/02/02 01:43
- 5.8 MB

- e._coli.jpeg
- 420×257
- 2023/01/26 15:17
- 19.5 KB

- e6.png
- 497×317
- 2021/03/01 23:49
- 240 KB

- ebselen_inhibitor.png
- 498×349
- 2021/01/30 13:22
- 57.1 KB

- ehre.jpeg
- 1800×624
- 2022/01/28 15:54
- 452.3 KB

- electrochemical_aptamer-based_sensors.png
- 882×608
- 2022/01/22 10:33
- 426.6 KB

- elisa.png
- 1194×728
- 2021/02/23 13:36
- 117.7 KB

- elisa1.png
- 624×462
- 2021/02/25 00:14
- 36 KB

- elisa11.png
- 550×396
- 2021/02/25 00:17
- 35.2 KB

- elisa_picture.png
- 713×470
- 2022/01/27 16:07
- 73.4 KB

- elisa_picture_v2.png
- 713×470
- 2022/01/27 16:11
- 73.4 KB

- elisa_results.png
- 1014×872
- 2021/02/24 20:18
- 323.3 KB

- entry.png
- 1539×1600
- 2021/02/01 09:14
- 649 KB

- envelopestructure.png
- 1424×584
- 2023/01/30 17:47
- 1.2 MB

- expoverview.png
- 560×411
- 2021/03/02 02:08
- 107.3 KB

- expoverview2.png
- 655×461
- 2021/03/01 23:22
- 141.9 KB

- extended_fig._8b.png
- 374×396
- 2023/03/02 12:56
- 44.7 KB

- extended_fig_4a.b.png
- 1270×756
- 2023/03/02 12:56
- 1.2 MB

- extended_figure_7b.png
- 530×440
- 2023/03/02 12:56
- 85.9 KB

- f1.large.jpg
- 1280×557
- 2021/01/31 12:42
- 56 KB

- f2.medium.jpg
- 1425×824
- 2022/01/27 15:22
- 288.5 KB

- ferret.png
- 1439×1090
- 2022/03/02 13:21
- 310.6 KB

- ferret2.png
- 897×682
- 2022/03/02 13:33
- 169.7 KB

- fig._5d.png
- 838×350
- 2023/03/02 12:56
- 190.2 KB

- fig1.png
- 502×649
- 2022/03/02 23:22
- 275.3 KB

- fig2.png
- 516×676
- 2022/03/02 23:29
- 507.2 KB

- fig2a.png
- 383×449
- 2023/03/02 15:41
- 39.5 KB

- fig2b.jpg
- 399×301
- 2023/03/02 15:41
- 23.6 KB

- fig3.png
- 627×757
- 2022/03/02 23:35
- 543.7 KB

- fig3a_mamou.png
- 1133×539
- 2023/03/02 03:37
- 227.9 KB

- fig3b_mamou.png
- 867×493
- 2023/03/02 03:37
- 191.9 KB

- fig3c_mamou.png
- 603×559
- 2023/03/02 03:37
- 200.4 KB

- fig3d_mamou.png
- 574×555
- 2023/03/02 03:37
- 122 KB

- fig3e_mamou.png
- 770×555
- 2023/03/02 03:37
- 80.5 KB

- fig4.png
- 528×667
- 2022/03/02 23:38
- 398.2 KB

- fig4a.png
- 1872×496
- 2022/03/03 00:57
- 1.2 MB

- fig4b.png
- 1879×445
- 2022/03/03 01:01
- 1.2 MB

- fig4d.png
- 1885×418
- 2022/03/03 01:05
- 850.4 KB

- fig4e.png
- 1867×685
- 2022/03/03 01:09
- 525.7 KB

- fig7.png
- 833×301
- 2023/02/01 21:21
- 67.7 KB

- fig8.png
- 623×398
- 2023/02/01 20:53
- 60 KB

- fig9.png
- 736×338
- 2023/02/01 20:57
- 44.1 KB

- fig10.png
- 538×345
- 2023/02/01 21:02
- 34.5 KB

- fig12.png
- 338×363
- 2023/02/01 21:12
- 49.4 KB

- fig_1-2.png
- 831×356
- 2023/02/01 19:24
- 127 KB

- fig_2a_4c03.jpg
- 358×549
- 2022/03/02 19:55
- 35.5 KB

- fig_2b_4c03.jpg
- 517×542
- 2022/03/02 20:01
- 47.1 KB

- fig_2c_4c03.jpg
- 374×605
- 2022/03/02 20:03
- 54.1 KB

- fig_2d_4c03.jpg
- 1275×678
- 2022/03/02 20:01
- 113.5 KB

- fig_2e_4c03.jpg
- 854×288
- 2022/03/02 20:05
- 46.4 KB

- fig_3.png
- 457×423
- 2023/02/01 19:16
- 58.8 KB

- fig_3_and_4.png
- 1402×627
- 2023/02/01 19:47
- 228.9 KB

- fig_4.png
- 457×308
- 2023/02/01 19:19
- 74.7 KB

- fig_5png.png
- 1202×406
- 2023/02/01 19:54
- 153.3 KB

- fig_6.png
- 343×586
- 2023/02/01 20:02
- 258.6 KB

- fig_13.png
- 778×310
- 2023/02/28 11:19
- 230.7 KB

- fig_14.png
- 797×508
- 2023/02/28 11:19
- 141 KB

- fig_20.png
- 397×436
- 2023/03/02 06:37
- 205.6 KB

- fig_21.png
- 877×565
- 2023/03/02 06:37
- 159.7 KB

- fig_22.png
- 1050×502
- 2023/03/02 07:11
- 141.5 KB

- fige6.png
- 430×515
- 2023/02/01 21:18
- 243 KB

- figu_6.png
- 343×586
- 2023/02/01 20:10
- 258.6 KB

- figure2d.png
- 1230×596
- 2021/03/02 01:25
- 974 KB

- figure2e.png
- 1428×624
- 2021/03/02 01:26
- 982.8 KB

- figure3a.png
- 1446×445
- 2021/02/27 15:32
- 243.9 KB

- figure3b.png
- 926×772
- 2021/02/28 12:15
- 223 KB

- figure3c.png
- 948×828
- 2021/02/28 12:19
- 299.6 KB

- figure3d.png
- 942×862
- 2021/02/28 12:22
- 274 KB

- figure3e.png
- 1476×612
- 2021/02/28 12:24
- 265.1 KB

- figure4a.png
- 1082×594
- 2021/02/28 12:29
- 205.5 KB

- figure4b.png
- 1174×410
- 2021/02/28 12:27
- 181 KB

- figure4c.png
- 746×380
- 2021/02/28 12:27
- 104.6 KB

- figure5.jpg
- 2046×1282
- 2022/02/27 12:36
- 182.1 KB

- figure5a_b.png
- 816×394
- 2023/03/02 12:56
- 260.2 KB

- figure7.png
- 3000×2100
- 2023/02/01 20:43
- 321.5 KB

- figure9e.png
- 169×184
- 2023/03/02 02:19
- 24.2 KB

- figure10-sciencetable.png
- 1584×634
- 2022/01/31 15:27
- 310.4 KB

- figure11-sciencetable.png
- 1822×585
- 2022/01/31 15:27
- 490.5 KB

- figure11.png
- 708×583
- 2023/02/01 21:08
- 122.4 KB

- figure_1.png
- 768×256
- 2023/03/01 15:31
- 176.8 KB

- figure_2.png
- 777×443
- 2021/02/01 18:34
- 119.2 KB

- figure_2_graph.png
- 421×345
- 2023/03/01 16:06
- 59.8 KB

- figure_2a_b.png
- 852×542
- 2023/03/02 12:56
- 652.9 KB

- figure_2b.png
- 776×380
- 2023/02/28 21:48
- 289.6 KB

- figure_2c.png
- 580×322
- 2023/02/28 21:50
- 191 KB

- figure_2d.png
- 414×436
- 2023/02/28 21:50
- 131.8 KB

- figure_2e.png
- 712×404
- 2023/02/28 21:50
- 395 KB

- figure_3.jpg
- 3600×1229
- 2022/03/03 03:25
- 624.4 KB

- figure_3.png
- 886×1082
- 2021/02/01 18:45
- 393 KB

- figure_3_ali.png
- 820×568
- 2021/02/28 15:27
- 60.5 KB

- figure_3_gel.png
- 453×393
- 2023/03/01 16:17
- 74.4 KB

- figure_3d.png
- 513×247
- 2023/03/01 00:29
- 66.2 KB

- figure_4.1.jpg
- 402×520
- 2023/02/02 14:11
- 28.1 KB

- figure_4.jpg
- 768×573
- 2023/02/02 13:22
- 50.3 KB

- figure_4.png
- 468×310
- 2021/02/01 18:53
- 67.8 KB

- figure_4_bar_graph.png
- 417×351
- 2023/03/01 16:26
- 90.1 KB

- figure_4_eab.jpeg
- 996×754
- 2022/02/25 17:14
- 168.5 KB

- figure_4_eab_specificity.jpeg
- 496×754
- 2022/02/28 15:58
- 118.9 KB

- figure_4_eab_speed.jpeg
- 504×754
- 2022/02/28 16:06
- 94.2 KB

- figure_4_graph.png
- 417×351
- 2023/03/01 16:25
- 90.1 KB

- figure_4a_b.png
- 1270×508
- 2023/03/02 12:56
- 645.8 KB

- figure_4c.png
- 277×166
- 2023/03/02 02:15
- 60.7 KB

- figure_4h.png
- 760×462
- 2021/02/27 01:15
- 183.2 KB

- figure_5.png
- 468×80
- 2021/02/01 18:55
- 17.4 KB

- figure_5_eab.jpeg
- 625×1087
- 2022/02/25 17:17
- 160.2 KB

- figure_5_harmy_.png
- 1272×612
- 2021/02/27 21:45
- 157.9 KB

- figure_5_line_graph.png
- 423×411
- 2023/03/01 16:30
- 122.2 KB

- figure_5h.png
- 750×514
- 2021/02/27 01:17
- 156.3 KB

- figure_6.png
- 468×301
- 2021/02/01 19:11
- 74.6 KB

- figure_6_eab.png
- 949×577
- 2022/02/25 17:17
- 113.1 KB

- figure_6_eab_new.png
- 579×453
- 2022/02/28 16:03
- 97.5 KB

- figure_6_harmy_.png
- 1252×707
- 2021/02/27 21:56
- 145.6 KB

- figure_6_km.png
- 463×393
- 2023/03/01 16:36
- 86.5 KB

- figure_6h.png
- 730×476
- 2021/02/27 01:21
- 131.6 KB

- figure_7.png
- 476×544
- 2021/02/27 01:24
- 160.2 KB

- figure_7_bar_graph_.png
- 388×358
- 2023/03/01 16:44
- 92.6 KB

- figure_7_harmy_.png
- 1069×719
- 2021/02/27 22:34
- 85.4 KB

- figure_8.png
- 410×600
- 2021/02/27 01:25
- 116.5 KB

- figure_8_harmy_.png
- 859×604
- 2021/02/27 22:37
- 60.1 KB

- figure_8_line_graph.png
- 379×361
- 2023/03/01 16:48
- 67 KB

- figure_9.png
- 340×500
- 2021/02/27 01:25
- 57.7 KB

- figure_9_a_b_harmy_.png
- 1245×556
- 2021/02/27 22:38
- 109.6 KB

- figure_9_bar_graph_.png
- 439×390
- 2023/03/01 16:50
- 95.6 KB

- figure_9a.png
- 291×113
- 2023/03/02 02:17
- 21.8 KB

- figure_9b.png
- 188×151
- 2023/03/02 02:18
- 16.8 KB

- figure_10.png
- 500×554
- 2023/03/01 21:21
- 180 KB

- figure_10_a_b_harmy_.png
- 1589×1156
- 2021/02/27 22:41
- 276.6 KB

- figure_11.jpg
- 332×418
- 2023/03/01 21:21
- 17 KB

- figure_12.png
- 648×328
- 2023/03/01 21:21
- 94.9 KB

- figure_13.jpg
- 360×398
- 2023/03/01 21:21
- 38.4 KB

- figure_14.png
- 670×254
- 2023/03/01 21:21
- 143 KB

- figure_15.png
- 460×592
- 2023/03/01 21:21
- 186.4 KB

- figure_16.png
- 584×356
- 2023/03/01 21:21
- 199.9 KB

- figure_17.png
- 778×316
- 2023/03/01 21:21
- 112.6 KB

- figure_18.png
- 936×366
- 2023/03/01 21:21
- 87.4 KB

- figure_19.png
- 1231×541
- 2023/03/02 06:37
- 69.9 KB

- first_cytometry_plot.jpg
- 3459×1110
- 2022/03/03 00:51
- 475.5 KB

- flow.png
- 1600×702
- 2021/02/01 23:44
- 378.6 KB

- full_mechanism_wiki.png
- 1010×435
- 2023/03/01 17:13
- 181.7 KB

- germ-layers-endoderm-ectoderm-desoderm.jpeg
- 450×185
- 2022/01/30 16:59
- 28.7 KB

- germinal_centre.png
- 3226×3859
- 2022/03/02 11:50
- 900.4 KB

- germinal_centre_2.png
- 3226×3859
- 2022/03/02 11:57
- 900.4 KB

- germinal_centre_3.png
- 3207×960
- 2022/03/02 12:01
- 355 KB

- germinalcentre1.png
- 700×700
- 2022/02/02 23:53
- 189.2 KB

- gnb_4c03.png
- 500×250
- 2023/01/30 21:47
- 91 KB

- gram_stain_2.png
- 1295×288
- 2023/01/30 13:11
- 188.2 KB

- gram_staining.png
- 1086×635
- 2023/01/30 12:50
- 249.1 KB

- graphic_overview.png
- 437×438
- 2021/02/20 22:34
- 98.9 KB

- group-1-part2-fig1.png
- 4030×1544
- 2022/02/17 21:22
- 780.9 KB

- group-1-part2-fig2.png
- 1280×632
- 2022/02/17 21:36
- 269.8 KB

- group-1-part2-fig3.png
- 1280×374
- 2022/02/17 22:15
- 106.5 KB

- group1-2022-fig1.png
- 3285×2465
- 2022/01/28 21:59
- 506.6 KB

- group1-2022-fig2.png
- 4360×2417
- 2022/01/29 14:11
- 1.7 MB

- group1-2022-fig3.png
- 3344×2503
- 2022/01/29 14:56
- 2.1 MB

- group1-2022-fig4.png
- 4075×522
- 2022/01/30 06:35
- 50.6 KB

- group1-2022-fig5.png
- 2677×2160
- 2022/01/30 08:40
- 376.1 KB

- group1-2022-fig6.png
- 1396×828
- 2022/01/30 09:00
- 99.9 KB

- group1-2022-fig7.png
- 2127×763
- 2022/01/30 09:21
- 224.4 KB

- group1-2022-fig8.png
- 1329×1074
- 2022/01/30 09:47
- 222.2 KB

- group1-2022-fig9.png
- 3906×2230
- 2022/01/30 13:04
- 1.3 MB

- group1-2022-fig10.png
- 3279×2361
- 2022/01/30 14:26
- 1.3 MB

- group1-2022-fig11.png
- 1190×1193
- 2022/01/30 15:11
- 1 MB

- group_3_-_4c03_presentation_2_.pdf
- 2021/03/02 00:07
- 2 MB

- hamster.png
- 1111×491
- 2022/03/02 13:21
- 113.9 KB

- hamster2.png
- 898×404
- 2022/03/02 13:33
- 98.7 KB

- hfh4production.png
- 1027×754
- 2021/03/01 23:30
- 240.9 KB

- hla.jpg
- 923×463
- 2022/01/27 15:29
- 44.1 KB

- humoral_immunity.png
- 892×478
- 2021/02/01 11:48
- 118.9 KB

- humoral_immunity_1_.png
- 2560×1250
- 2021/02/28 15:30
- 553.3 KB

- humoralvscellmediated.png
- 871×627
- 2022/03/02 17:00
- 527.9 KB

- imai.png
- 1054×638
- 2023/02/01 13:35
- 1 MB

- immune_cells.png
- 703×450
- 2022/01/20 15:26
- 140.7 KB

- immunity.png
- 566×417
- 2021/01/31 02:12
- 71.2 KB

- immunity_2_1_.png
- 463×349
- 2021/01/31 23:03
- 40.2 KB

- immuno_aspects.png
- 895×497
- 2021/02/01 11:54
- 45.6 KB

- immunological_aspects.png
- 548×589
- 2021/02/01 01:52
- 74.9 KB

- immunological_aspects_1_.png
- 843×363
- 2021/02/01 11:52
- 179.2 KB

- inactivatedvaccine.pdf
- 2022/01/31 12:34
- 11.5 KB

- inactivatedvaccine.png
- 586×586
- 2022/01/31 12:38
- 253.3 KB

- inner_membrane_lptb2fg.png
- 446×852
- 2023/02/02 16:34
- 480 KB

- intensity.png
- 1296×1000
- 2023/02/15 23:18
- 442.4 KB

- intrinsic_barrier.png
- 869×543
- 2021/02/01 01:53
- 310.8 KB

- ivig.jpg
- 420×300
- 2021/01/31 17:18
- 36.7 KB

- journal.ppat.1009885.g001.png
- 2050×2610
- 2022/01/30 20:35
- 2.3 MB

- karlagroup31a.png
- 1830×1280
- 2023/03/01 22:39
- 729.7 KB

- karlagroup31b.png
- 1325×2542
- 2023/03/01 22:45
- 2.5 MB

- karlagroup31c.png
- 1467×1300
- 2023/03/01 22:59
- 1.3 MB

- l.jpg
- 2000×1005
- 2021/02/01 23:23
- 197.1 KB

- l_2438_1dfc13ab2f39b2c531fb43183156ff14.png
- 940×469
- 2022/02/28 15:31
- 143 KB

- leonfigure.png
- 766×664
- 2023/03/02 06:47
- 193.1 KB

- leonfigures.png
- 637×478
- 2023/03/02 06:55
- 97.1 KB

- lewis.jpg
- 1500×2106
- 2023/02/01 13:33
- 923.2 KB

- lfa_pic_1.png
- 506×218
- 2022/01/27 15:42
- 59.7 KB

- lfa_pic_2.png
- 588×252
- 2022/01/27 15:45
- 135.8 KB

- lfa_pic_3.png
- 356×410
- 2022/01/27 15:46
- 97.4 KB

- licavity.png
- 678×323
- 2023/03/02 03:17
- 328.2 KB

- lifecycles.png
- 1562×1092
- 2021/02/01 18:32
- 1.5 MB

- lim.png
- 886×572
- 2021/02/01 23:47
- 158.2 KB

- liveattenuatedvaccine.png
- 603×630
- 2022/01/31 12:46
- 287.3 KB

- lod01.png
- 1600×451
- 2021/03/01 22:11
- 148.1 KB

- lod_1.png
- 512×144
- 2021/03/01 22:00
- 27.7 KB

- lps_strucutre_highest_res_purple.png
- 1036×636
- 2023/02/02 00:25
- 110 KB

- macrophage_phagocytosis.png
- 491×472
- 2021/02/01 13:25
- 220.1 KB

- mamou.jpg
- 563×824
- 2023/01/19 15:24
- 93.7 KB

- march_frequency.png
- 1220×316
- 2021/01/26 13:19
- 336.8 KB

- mbc_screening.png
- 1314×499
- 2021/02/23 13:14
- 94.8 KB

- mechanismsofade.jpg
- 1999×1384
- 2022/02/27 12:48
- 389 KB

- memory_b_cells.jpg
- 1154×758
- 2022/01/29 20:44
- 83.1 KB

- memory_t_cells.jpg
- 1118×681
- 2022/01/28 23:48
- 59.5 KB

- meyer.jpeg
- 400×400
- 2023/02/01 13:33
- 35 KB

- microsoftteams-image.png
- 884×465
- 2021/02/02 03:31
- 318.4 KB

- microsoftteams-image_1_.png
- 1589×759
- 2021/02/02 03:42
- 945.8 KB

- mlafedb_complex.png
- 1322×622
- 2023/02/01 17:35
- 737.7 KB

- modesoft.png
- 1600×1120
- 2021/02/01 09:10
- 211.4 KB

- molecules-25-01340-g002.jpg
- 748×428
- 2023/02/02 00:06
- 85.9 KB

- monkey.png
- 921×727
- 2022/03/02 13:21
- 158 KB

- monkey2.png
- 872×678
- 2022/03/02 17:10
- 188.8 KB

- monkey3.png
- 872×678
- 2022/03/02 17:12
- 188.8 KB

- mscs.png
- 3000×2100
- 2022/02/02 10:13
- 538.7 KB

- murepavadin_wiki.png
- 421×316
- 2023/03/01 17:06
- 59.1 KB

- nacidvaccine.png
- 622×600
- 2022/01/31 13:02
- 206.4 KB

- neutralization_assay_results.png
- 258×387
- 2021/02/24 20:39
- 52.6 KB

- neutralizing_ab.png
- 600×697
- 2021/02/02 00:43
- 154.3 KB

- newomp.png
- 1446×676
- 2023/02/01 15:01
- 702.2 KB

- nucleic_acid_vaccine.jpg
- 3961×2377
- 2022/01/27 15:23
- 200.8 KB

- nucleoside_analog.pdf
- 2021/01/30 13:12
- 111.8 KB

- nucleoside_analog.png
- 718×401
- 2021/01/30 13:15
- 150.5 KB

- o.png
- 899×651
- 2021/02/01 23:28
- 183.4 KB

- of4kvmqqlmcwxdj33xf1_inflammation-by-dr-amit-suryawanshi-oral-maxillofacial-surgeon-pune-india-9-638.jpeg
- 638×479
- 2022/01/26 18:05
- 101.9 KB

- omp.png
- 1594×716
- 2023/02/01 13:32
- 878.1 KB

- omp_bama.png
- 1250×332
- 2023/02/02 00:13
- 521.7 KB

- ompgreenred.png
- 1168×594
- 2023/02/02 00:11
- 1.1 MB

- omppg.png
- 1692×490
- 2023/02/15 23:34
- 507.2 KB

- openhrt-2020-december-7-2--f1.large.jpg
- 1280×833
- 2022/01/31 23:02
- 132.8 KB

- other_cas_pro.png
- 512×304
- 2021/03/01 22:35
- 55.8 KB

- outer_membrane_lptge.png
- 728×686
- 2023/02/02 16:38
- 510.3 KB

- p-best.jpg
- 870×1019
- 2021/02/02 00:12
- 187.1 KB

- p.png
- 517×236
- 2021/02/02 00:14
- 74.6 KB

- pasted_image_0.png
- 700×393
- 2021/02/01 12:58
- 225.4 KB

- pathogenesis_transmission.pdf
- 2021/02/02 07:20
- 3.5 MB

- periplasmic_bridge_lptcad.png
- 458×656
- 2023/02/02 16:36
- 148 KB

- phage_display.png
- 615×269
- 2022/03/02 21:14
- 52.4 KB

- phagocytosis.png
- 353×409
- 2021/02/01 01:53
- 188.9 KB

- photocrosslinking.png
- 990×644
- 2023/03/01 14:57
- 199.1 KB

- picture1.png
- 326×317
- 2022/02/27 15:33
- 184.8 KB

- picture2.png
- 376×596
- 2022/02/25 17:09
- 209.9 KB

- picture3.png
- 398×572
- 2022/02/25 17:10
- 274.1 KB

- pneumoniastain.jpg
- 560×765
- 2021/03/02 02:09
- 456.5 KB

- predicted_mech_darobactin.png
- 529×579
- 2023/02/01 17:42
- 157.6 KB

- prefusion_and_postfusion_spike.png
- 2534×1230
- 2021/01/31 22:53
- 2.3 MB

- presentation_two.pptx
- 2021/03/01 23:52
- 10.5 MB

- proteinsubunitvaccine.png
- 553×537
- 2022/01/31 13:02
- 192.3 KB

- pseudovirus_neutralization_assay.png
- 1083×735
- 2021/02/24 20:35
- 170.9 KB

- rbd.jpg
- 312×341
- 2022/01/30 13:13
- 32.6 KB

- rbdconformations.png
- 907×696
- 2022/01/31 18:07
- 425.9 KB

- rechallenge.png
- 558×188
- 2021/03/01 23:47
- 51.4 KB

- rechallengesurvival.png
- 295×177
- 2021/03/01 23:48
- 11.2 KB

- rechallengeweight.png
- 369×190
- 2021/03/01 23:48
- 26.9 KB

- red-checkmark-227003.png
- 616×768
- 2022/02/02 22:31
- 16.8 KB

- red_green.png
- 785×445
- 2023/03/02 00:19
- 123 KB

- reproterol_binding_to_ace2.png
- 658×325
- 2021/01/30 13:24
- 193.7 KB

- results1.png
- 816×478
- 2022/03/02 22:45
- 151.7 KB

- results3.png
- 822×354
- 2022/03/02 22:45
- 169.1 KB

- results4.png
- 1270×525
- 2022/03/02 22:45
- 272.7 KB

- rt-pcr.png
- 2190×778
- 2022/01/27 15:49
- 233.4 KB

- s_protein_ace2_receptor.jpg
- 714×698
- 2021/01/23 12:25
- 48.1 KB

- s_protein_homotrimer.jpg
- 802×836
- 2021/01/23 12:25
- 61.9 KB

- sars-cov-2_genome_map.png
- 862×296
- 2021/01/23 11:07
- 77.8 KB

- sars-cov-2_genome_map_1_.png
- 1812×666
- 2021/01/23 12:53
- 325.3 KB

- sars-cov_2_structure.jpg
- 800×692
- 2022/01/27 15:17
- 109.6 KB

- sars-cov_bmi_heat_map.png
- 527×546
- 2021/02/23 23:29
- 62.6 KB

- sars-cov_epitope_binning.png
- 712×649
- 2021/02/25 20:12
- 338.3 KB

- sarscov2_genome_.jpg
- 1745×623
- 2022/01/31 18:57
- 168.2 KB

- sarscov2_genome_2_.jpg
- 1681×591
- 2022/02/02 20:41
- 162.4 KB

- sarscov2variants.png
- 1203×875
- 2022/01/31 19:10
- 209.7 KB

- sarstransmission.jpg
- 2485×1829
- 2022/02/02 00:19
- 338.8 KB

- scitranslmed.abi8961-f1.jpg
- 937×2557
- 2022/03/02 23:49
- 243.5 KB

- scitranslmed.abi8961-f2.jpg
- 3600×1270
- 2022/03/03 00:41
- 602.8 KB

- scitranslmed.abi8961-f5_1_.jpg
- 3600×3754
- 2022/03/02 22:45
- 1.9 MB

- screen_shot_2021-01-30_at_11.03.28_am.png
- 562×734
- 2021/01/30 11:05
- 445.5 KB

- screen_shot_2021-01-31_at_10.40.04_pm.png
- 1336×1220
- 2021/01/31 22:41
- 1.2 MB

- screen_shot_2021-02-23_at_11.24.27_pm.png
- 527×546
- 2021/02/23 23:24
- 62.6 KB

- screen_shot_2021-02-25_at_8.30.47_pm.png
- 368×360
- 2021/02/25 20:36
- 78.9 KB

- screen_shot_2021-02-25_at_8.46.17_pm.png
- 498×574
- 2021/02/25 21:03
- 90.3 KB

- screen_shot_2021-02-25_at_9.40.16_pm.png
- 296×611
- 2021/02/25 21:40
- 68.2 KB

- screen_shot_2021-02-26_at_5.33.39_pm.png
- 2432×1258
- 2021/02/26 19:57
- 350.5 KB

- screen_shot_2021-02-26_at_8.35.21_pm.png
- 728×792
- 2021/02/26 20:36
- 107.8 KB

- screen_shot_2021-02-26_at_8.35.21_pm_1_.png
- 728×775
- 2021/02/26 20:47
- 105.6 KB

- screen_shot_2021-02-27_at_4.50.15_pm.png
- 652×569
- 2021/02/27 16:52
- 93.9 KB

- screen_shot_2021-02-27_at_6.37.06_pm.png
- 861×506
- 2021/02/27 18:37
- 170.3 KB

- screen_shot_2021-02-27_at_6.38.10_pm.png
- 840×403
- 2021/02/27 18:38
- 271.2 KB

- screen_shot_2021-02-27_at_11.39.59_am.png
- 2059×1006
- 2021/02/27 14:38
- 435.7 KB

- screen_shot_2021-03-01_at_9.55.48_pm.png
- 805×422
- 2021/03/01 21:57
- 296.5 KB

- screen_shot_2021-03-01_at_10.00.55_pm.png
- 911×441
- 2021/03/01 22:01
- 151.9 KB

- screen_shot_2021-03-01_at_10.04.58_pm.png
- 492×451
- 2021/03/01 22:05
- 83.2 KB

- screen_shot_2021-03-01_at_10.09.37_pm.png
- 839×453
- 2021/03/01 22:09
- 270 KB

- screen_shot_2021-03-01_at_10.11.18_pm.png
- 607×370
- 2021/03/01 22:11
- 110.9 KB

- screen_shot_2021-03-01_at_10.14.48_pm.png
- 795×297
- 2021/03/01 22:15
- 120.9 KB

- screen_shot_2021-03-01_at_10.17.12_pm.png
- 783×316
- 2021/03/01 22:17
- 178.9 KB

- screen_shot_2021-03-01_at_10.18.58_pm.png
- 812×296
- 2021/03/01 22:19
- 128.3 KB

- screen_shot_2021-03-02_at_8.24.30_am.png
- 766×746
- 2021/03/02 08:24
- 425.6 KB

- screen_shot_2021-03-02_at_12.56.53_am.png
- 1352×678
- 2021/03/02 00:58
- 899.8 KB

- screen_shot_2022-01-22_at_9.35.12_am.jpg
- 1950×940
- 2022/01/22 09:37
- 69 KB

- screen_shot_2022-01-22_at_9.47.25_am.png
- 2444×1038
- 2022/01/22 09:49
- 1.9 MB

- screen_shot_2022-01-22_at_10.26.22_am.png
- 882×608
- 2022/01/22 10:32
- 426.6 KB

- screen_shot_2022-01-26_at_6.09.53_pm.png
- 995×586
- 2022/01/26 18:10
- 425.1 KB

- screen_shot_2022-01-27_at_3.25.30_pm.png
- 962×910
- 2022/01/27 15:26
- 415.2 KB

- screen_shot_2022-01-29_at_12.18.53_pm.png
- 1432×1062
- 2022/01/29 12:19
- 1007.4 KB

- screen_shot_2022-01-30_at_5.27.02_pm.png
- 711×413
- 2022/01/30 17:27
- 157.9 KB

- screen_shot_2022-01-30_at_8.14.38_pm.png
- 1014×668
- 2022/01/30 20:25
- 212.8 KB

- screen_shot_2022-01-31_at_6.26.08_pm.png
- 384×344
- 2022/01/31 18:26
- 143.2 KB

- screen_shot_2022-01-31_at_6.39.07_pm.png
- 1146×628
- 2022/01/31 18:39
- 544.4 KB

- screen_shot_2022-02-01_at_1.58.06_pm.png
- 491×379
- 2022/02/01 14:02
- 76.9 KB

- screen_shot_2022-02-02_at_8.33.41_pm.png
- 1002×782
- 2022/02/02 20:39
- 353.8 KB

- screen_shot_2022-02-22_at_7.31.14_pm.png
- 742×608
- 2022/02/22 19:31
- 500.1 KB

- screen_shot_2022-02-23_at_5.09.18_pm.png
- 805×564
- 2022/02/23 17:10
- 267.1 KB

- screen_shot_2022-02-23_at_5.11.25_pm.png
- 1168×615
- 2022/02/23 17:12
- 668 KB

- screen_shot_2022-02-23_at_8.20.48_pm.png
- 1288×296
- 2022/02/23 20:21
- 365.5 KB

- screen_shot_2022-02-23_at_8.20.58_pm.png
- 626×315
- 2022/02/23 20:22
- 83.7 KB

- screen_shot_2022-02-23_at_12.09.30_pm.png
- 636×448
- 2022/02/23 12:10
- 286.6 KB

- screen_shot_2022-02-23_at_12.09.54_pm.png
- 502×450
- 2022/02/23 12:11
- 160.1 KB

- screen_shot_2022-02-24_at_2.24.23_pm.png
- 636×612
- 2022/02/24 16:19
- 109.9 KB

- screen_shot_2022-02-24_at_2.53.18_pm.png
- 512×291
- 2022/02/24 14:53
- 43.8 KB

- screen_shot_2022-02-24_at_2.55.06_pm.png
- 366×438
- 2022/02/24 14:55
- 63.7 KB

- screen_shot_2022-02-24_at_3.12.53_pm.png
- 1305×379
- 2022/02/24 15:13
- 155.7 KB

- screen_shot_2022-02-24_at_3.36.01_pm.png
- 1374×255
- 2022/02/24 15:36
- 146.9 KB

- screen_shot_2022-02-24_at_3.36.46_pm.png
- 1344×288
- 2022/02/24 15:37
- 675.9 KB

- screen_shot_2022-02-24_at_4.23.04_pm.png
- 1072×686
- 2022/02/24 16:23
- 219.4 KB

- screen_shot_2022-02-24_at_4.31.15_pm.png
- 1198×616
- 2022/02/24 16:31
- 192.7 KB

- screen_shot_2022-02-24_at_4.42.46_pm.png
- 1982×872
- 2022/02/24 16:44
- 1.4 MB

- screen_shot_2022-02-24_at_4.48.21_pm.png
- 2472×1324
- 2022/02/24 16:50
- 863.8 KB

- screen_shot_2022-02-24_at_6.21.22_pm.png
- 1275×699
- 2022/02/24 18:22
- 403.2 KB

- screen_shot_2022-02-25_at_1.21.19_am.png
- 1742×388
- 2022/02/26 17:37
- 287.8 KB

- screen_shot_2022-02-25_at_1.56.23_pm.png
- 1364×386
- 2022/02/25 13:57
- 129.5 KB

- screen_shot_2022-02-25_at_2.18.18_pm.png
- 1054×396
- 2022/02/26 20:09
- 268 KB

- screen_shot_2022-02-25_at_2.24.11_pm.png
- 1172×308
- 2022/02/26 20:12
- 252.3 KB

- screen_shot_2022-02-25_at_2.30.35_am.png
- 1382×558
- 2022/02/26 17:43
- 659.1 KB

- screen_shot_2022-02-25_at_2.37.17_pm.png
- 484×574
- 2022/02/26 20:14
- 95.8 KB

- screen_shot_2022-02-25_at_3.03.29_am.png
- 1150×442
- 2022/02/26 19:52
- 249.5 KB

- screen_shot_2022-02-25_at_3.14.01_am.png
- 1366×262
- 2022/02/26 19:58
- 210 KB

- screen_shot_2022-02-25_at_6.00.45_pm.png
- 684×672
- 2022/02/26 20:20
- 188.6 KB

- screen_shot_2022-02-25_at_11.50.43_pm.png
- 506×574
- 2022/02/26 20:23
- 100.7 KB

- screen_shot_2022-02-25_at_11.54.38_pm.png
- 424×444
- 2022/02/26 20:27
- 80.3 KB

- screen_shot_2022-02-25_at_11.55.18_pm.png
- 1260×326
- 2022/02/26 20:31
- 312.7 KB

- screen_shot_2022-02-25_at_11.57.08_pm.png
- 520×508
- 2022/02/26 20:34
- 119.2 KB

- screen_shot_2022-02-25_at_11.57.45_pm.png
- 676×544
- 2022/02/26 20:42
- 124.3 KB

- screen_shot_2022-02-25_at_12.57.29_pm.png
- 522×886
- 2022/02/26 20:01
- 355.8 KB

- screen_shot_2022-02-26_at_10.17.49_pm.png
- 2592×596
- 2022/02/26 22:18
- 353.4 KB

- screen_shot_2022-02-27_at_4.08.12_pm.png
- 782×1248
- 2022/02/27 16:08
- 1 MB

- screen_shot_2022-02-27_at_5.55.16_pm.png
- 1286×752
- 2022/02/27 17:59
- 316 KB

- screen_shot_2022-02-27_at_5.55.44_pm.png
- 1257×234
- 2022/02/27 18:01
- 114.3 KB

- screen_shot_2022-02-27_at_8.29.33_pm.png
- 1680×479
- 2022/02/27 20:30
- 488.3 KB

- screen_shot_2022-02-27_at_9.07.55_pm.png
- 1717×428
- 2022/02/27 21:08
- 491.2 KB

- screen_shot_2022-02-27_at_10.44.44_pm.png
- 1369×378
- 2022/02/27 22:45
- 126.6 KB

- screen_shot_2022-02-27_at_12.45.17_pm.png
- 2552×542
- 2022/02/27 14:17
- 340.4 KB

- screen_shot_2022-02-28_at_1.39.34_pm.png
- 1672×366
- 2022/02/28 13:49
- 291.1 KB

- screen_shot_2022-02-28_at_1.40.02_pm.png
- 1118×418
- 2022/02/28 13:54
- 487.7 KB

- screen_shot_2022-02-28_at_1.40.20_pm.png
- 766×268
- 2022/02/28 13:55
- 129.3 KB

- screen_shot_2022-02-28_at_1.40.31_pm.png
- 1138×236
- 2022/02/28 13:56
- 158.9 KB

- screen_shot_2022-02-28_at_1.40.52_pm.png
- 366×654
- 2022/02/28 13:59
- 180.1 KB

- screen_shot_2022-02-28_at_1.41.26_pm.png
- 1346×478
- 2022/02/28 14:00
- 373.4 KB

- screen_shot_2022-02-28_at_1.41.38_pm.png
- 1828×488
- 2022/02/28 14:01
- 520.9 KB

- screen_shot_2022-02-28_at_1.41.50_pm.png
- 644×760
- 2022/02/28 14:02
- 142.2 KB

- screen_shot_2022-02-28_at_1.41.58_pm.png
- 740×734
- 2022/02/28 14:03
- 223.5 KB

- screen_shot_2022-02-28_at_1.42.07_pm.png
- 648×728
- 2022/02/28 14:04
- 148.5 KB

- screen_shot_2022-02-28_at_1.42.17_pm.png
- 624×718
- 2022/02/28 14:05
- 162.2 KB

- screen_shot_2022-02-28_at_1.42.30_pm.png
- 1824×622
- 2022/02/28 14:05
- 695.4 KB

- screen_shot_2022-02-28_at_1.42.40_pm.png
- 708×668
- 2022/02/28 14:08
- 168.9 KB

- screen_shot_2022-02-28_at_1.42.48_pm.png
- 908×638
- 2022/02/28 14:09
- 173.4 KB

- screen_shot_2022-02-28_at_1.55.03_am.png
- 332×221
- 2022/02/28 02:03
- 33.6 KB

- screen_shot_2022-02-28_at_1.55.14_am.jpg
- 1254×263
- 2022/02/28 02:03
- 61.5 KB

- screen_shot_2022-02-28_at_1.57.38_am.png
- 347×227
- 2022/02/28 02:03
- 37.3 KB

- screen_shot_2022-02-28_at_1.57.48_am.png
- 521×201
- 2022/02/28 02:07
- 63.3 KB

- screen_shot_2022-02-28_at_1.58.34_am.jpg
- 706×309
- 2022/02/28 02:03
- 54.5 KB

- screen_shot_2022-02-28_at_1.58.44_am.jpg
- 1254×341
- 2022/02/28 02:03
- 78.6 KB

- screen_shot_2022-03-02_at_1.13.59_pm.png
- 795×526
- 2022/03/02 13:14
- 190.3 KB

- screen_shot_2022-03-02_at_8.26.19_pm.png
- 1228×364
- 2022/03/02 20:27
- 143 KB

- screen_shot_2022-03-02_at_8.26.27_pm.png
- 1198×918
- 2022/03/02 20:31
- 355.8 KB

- screen_shot_2022-03-02_at_8.26.34_pm.png
- 1138×914
- 2022/03/02 20:33
- 352.6 KB

- screen_shot_2022-03-02_at_9.25.26_pm.png
- 1976×1080
- 2022/03/02 21:26
- 573.1 KB

- screen_shot_2023-01-29_at_10.30.09_pm.png
- 1100×618
- 2023/01/30 13:13
- 238.6 KB

- screen_shot_2023-01-30_at_2.41.10_pm.png
- 590×1066
- 2023/01/30 14:47
- 185.6 KB

- screen_shot_2023-02-01_at_1.39.26_pm.png
- 926×504
- 2023/02/01 18:27
- 353.9 KB

- screen_shot_2023-02-01_at_3.19.59_pm.png
- 512×318
- 2023/02/01 15:20
- 36.8 KB

- screen_shot_2023-02-01_at_5.10.31_pm.png
- 1242×516
- 2023/02/01 17:12
- 615.5 KB

- screen_shot_2023-02-01_at_5.10.45_pm.png
- 886×852
- 2023/02/01 17:12
- 496.7 KB

- screen_shot_2023-02-01_at_5.11.21_pm.png
- 672×616
- 2023/02/01 17:12
- 271.3 KB

- screen_shot_2023-02-01_at_6.36.14_pm.png
- 362×364
- 2023/02/01 18:36
- 187.8 KB

- screen_shot_2023-02-01_at_6.38.26_pm.png
- 378×374
- 2023/02/01 18:38
- 171.2 KB

- screen_shot_2023-02-01_at_6.39.18_pm.png
- 362×364
- 2023/02/01 18:39
- 120.7 KB

- screen_shot_2023-02-01_at_6.39.52_pm.png
- 352×364
- 2023/02/01 18:40
- 232.4 KB

- screen_shot_2023-02-01_at_10.51.04_pm.png
- 1630×1058
- 2023/02/01 22:51
- 310.5 KB

- screen_shot_2023-02-01_at_12.13.34_pm.png
- 864×412
- 2023/02/01 18:29
- 90.8 KB

- screen_shot_2023-02-28_at_4.15.22_pm.png
- 1030×488
- 2023/02/28 16:16
- 450.4 KB

- screen_shot_2023-02-28_at_4.20.37_pm.png
- 1372×484
- 2023/02/28 16:21
- 615.4 KB

- screen_shot_2023-02-28_at_4.22.19_pm.png
- 814×784
- 2023/02/28 16:22
- 434.7 KB

- screen_shot_2023-02-28_at_4.23.53_pm.png
- 2384×1034
- 2023/02/28 16:24
- 1.7 MB

- screen_shot_2023-03-01_at_2.55.32_pm.png
- 978×646
- 2023/03/01 14:55
- 198.6 KB

- screen_shot_2023-03-01_at_7.12.13_pm.png
- 1000×388
- 2023/03/01 19:11
- 339.2 KB

- screen_shot_2023-03-01_at_8.27.53_pm.png
- 1584×1030
- 2023/03/01 20:28
- 838 KB

- screen_shot_2023-03-01_at_8.53.55_pm.png
- 570×322
- 2023/03/01 20:54
- 39.5 KB

- screen_shot_2023-03-01_at_9.05.32_pm-min.png
- 846×415
- 2023/03/01 21:25
- 28.8 KB

- screen_shot_2023-03-02_at_2.13.02_am.png
- 245×247
- 2023/03/02 02:13
- 76.8 KB

- screenshot_50_.png
- 1920×1080
- 2021/03/01 16:49
- 472.9 KB

- screenshot_2021-03-02_065307.png
- 505×459
- 2021/03/02 06:55
- 48.9 KB

- screenshot_2022-03-03_014128.png
- 427×157
- 2022/03/03 01:50
- 27.6 KB

- screenshot_2022-03-03_014535.png
- 617×452
- 2022/03/03 01:50
- 120.5 KB

- screenshot_2022-03-03_014615.png
- 527×467
- 2022/03/03 01:50
- 126.4 KB

- screenshot_2022-03-03_015809.png
- 704×331
- 2022/03/03 01:58
- 59.4 KB

- screenshot_2022-03-03_021258.jpg
- 538×442
- 2022/03/03 02:19
- 25.9 KB

- screenshot_2022-03-03_021258.png
- 538×442
- 2022/03/03 02:14
- 71.5 KB

- screenshot_2023-02-27_191104.jpg
- 876×394
- 2023/03/01 06:55
- 63.9 KB

- screenshot_2023-03-02_at_6.33.54_pm.png
- 452×586
- 2023/03/02 18:38
- 72 KB

- septal.png
- 584×642
- 2023/02/15 23:18
- 97.4 KB

- significance_of_mouse_model.png
- 3000×2100
- 2021/02/27 18:32
- 590.7 KB

- spike-ace2_binding.png
- 233×226
- 2021/01/23 12:19
- 43.8 KB

- spike_protein_homotrimer.png
- 214×227
- 2021/01/23 12:19
- 44.1 KB

- spikeproteinattachment.png
- 1634×1221
- 2022/01/30 12:43
- 950.1 KB

- staining_assay.png
- 497×231
- 2021/02/23 19:49
- 33.7 KB

- stellar_corona.png
- 371×180
- 2021/01/23 11:40
- 125.7 KB

- structure.png
- 625×290
- 2021/02/01 14:30
- 117.8 KB

- structure1.png
- 1584×990
- 2022/02/02 17:38
- 305.7 KB

- summary-of-cytokines-and-their-functions.png
- 850×884
- 2021/02/26 19:51
- 94.2 KB

- summary_table1.png
- 1044×522
- 2021/01/31 19:09
- 65.7 KB

- symptom_age.png
- 385×427
- 2021/02/01 21:10
- 61.6 KB

- systemic.jpg
- 710×621
- 2022/01/27 19:07
- 77.6 KB

- table_1.png
- 936×540
- 2023/03/01 21:21
- 67.5 KB

- table_2.png
- 1264×1378
- 2021/02/26 20:57
- 179.1 KB

- table_pros_and_cons_therapy.jpg
- 701×523
- 2022/02/03 00:25
- 86.7 KB

- testing_strip.png
- 512×242
- 2021/03/01 22:28
- 69.7 KB

- thanatin_wiki.png
- 410×668
- 2023/03/01 17:02
- 87.1 KB

- therapy_pros_and_cons.jpg
- 701×523
- 2022/02/03 00:26
- 86.7 KB

- theurapeutic_targeting_of_sars-cov-2_presentation_1_-_group_3_biochem_4c03.pdf
- 2022/02/03 00:51
- 1.4 MB

- tim20.png
- 790×457
- 2022/02/03 06:38
- 186.9 KB

- tim21.png
- 607×424
- 2022/02/03 06:54
- 359.1 KB

- tim22.png
- 472×475
- 2022/02/03 06:48
- 234.4 KB

- tim23.png
- 687×460
- 2022/02/03 06:35
- 294.1 KB

- transgenic_mouse_studies.png
- 960×720
- 2021/02/27 17:13
- 314.3 KB

- transport_inner_membrane_.png
- 866×848
- 2023/02/02 16:51
- 505.7 KB

- transport_periplasmic.png
- 566×842
- 2023/02/02 16:53
- 226.6 KB

- transport_proteins.png
- 1034×922
- 2023/02/02 16:46
- 325.9 KB

- transport_system.png
- 1086×918
- 2023/02/02 13:11
- 310.4 KB

- tropism.png
- 553×410
- 2021/03/01 23:33
- 74.8 KB

- u.png
- 996×678
- 2021/02/01 23:36
- 463.3 KB

- unemployment.png
- 696×324
- 2021/01/31 16:51
- 7.7 KB

- unnamed.png
- 512×163
- 2021/02/02 00:10
- 35.3 KB

- untitled-4.png
- 3000×2100
- 2023/02/02 13:03
- 1.7 MB

- untitled.png
- 1575×578
- 2021/02/01 01:21
- 30.3 KB

- untitled1.png
- 983×342
- 2023/02/02 10:58
- 125.9 KB

- untitled_copy.png
- 3000×2100
- 2022/02/02 10:38
- 665.9 KB

- vaccines_2.jpg
- 1200×900
- 2021/01/31 22:12
- 90 KB

- viral_lifecycle.png
- 2127×2154
- 2022/01/27 18:49
- 939.9 KB

- viraltiter.png
- 657×484
- 2021/03/01 23:33
- 49.1 KB

- viralvectorvaccine.png
- 511×565
- 2022/01/31 13:02
- 271.1 KB

- virion_structure.png
- 3000×1800
- 2021/01/31 22:53
- 622.8 KB

- visualization_1_.png
- 512×410
- 2021/03/01 21:27
- 36.9 KB

- visualization_2_.png
- 1544×884
- 2021/03/01 21:28
- 245.7 KB

- visualization_3_.png
- 982×450
- 2021/03/01 21:31
- 126.9 KB

- vollmer.jpg
- 150×150
- 2023/01/19 15:21
- 5.2 KB

- wbcanalysis.png
- 822×424
- 2021/03/01 23:32
- 113.6 KB
File
- View
- History